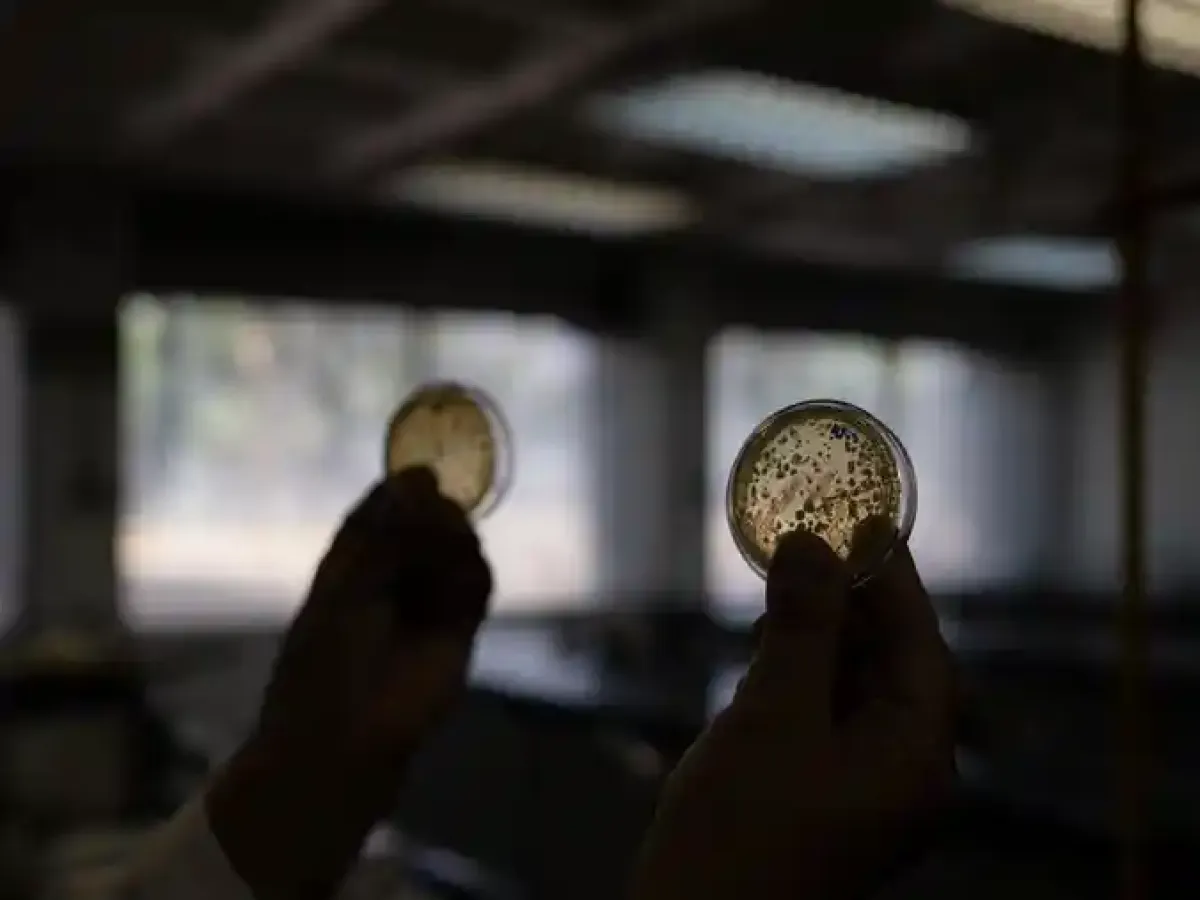
thumb

Jakarta: Kapolri Jenderal Listyo Sigit Prabowo bersama Ketua Komisi IV DPR Siri Hediati Hariyadi meninjau lokasi Hunian Sementara (Huntara) Asrama Haji Pinangsori untuk korban bencana di wilayah Tapanuli Tengah, Sumatra Utara. Kunjungan ini untuk melihat situasi dan kondisi terkini masyarakat yang sempat terkena bencana banjir dan longsor, serta mengetahui kebutuhan para korban.
"Hari ini kami bersama-sama dengan Ibu Ketua Komisi IV bisa berinteraksi untuk mendengarkan langsung dan melihat situasi dan kondisi masyarakat khususnya yang mengungsi sementara di huntara," jelas Kapolri dalam keterangannya, Minggu, 15 Februari 2026.
Dalam kunjungan tersebut, Listyo mengatakan pihaknya akan menyalurkan total 16 truk bantuan kemanusiaan untuk Huntara Asrama Haji Pinangsori dan tempat lainnya di Tapanuli Tengah yang masih membutuhkan.
Dia menjelaskan proses penyaluran bantuan akan dibantu oleh Bupati Tapanuli Tengah Masinton Pasaribu sesuai dengan kebutuhannya di masing-masing lokasi. Selain itu, kata dia, ada bantuan kemanusiaan yang turut diberikan Titiek Soeharto selaku Ketua Komisi IV DPR.
"Ada kurang lebih 16 truk yang akan kami salurkan baik di huntara ini maupun di kabupaten-kabupaten yang ada di wilayah Tapteng. Nanti Pak Bupati yang akan membagi terkait kebutuhan yang diperlukan seperti pakaian, bahan makanan, obat, snack dan juga ada bantuan dari Ibu Ketua Komisi IV," ujar dia.
Baca Juga: Percepat Pemulihan Akses, Kapolri Pantau Pembangunan Jembatan Bailey di Sumbar
Kapolri Jenderal Listyo Sigit Prabowo meninjau lokasi Hunian Sementara (Huntara) Asrama Haji Pinangsori untuk korban bencana di wilayah Tapanuli Tengah, Sumatra Utara. Dok. Istimewa
Selain itu, kata dia, terdapat bantuan berupa seragam sekolah, buku pelajaran serta tas untuk para siswa yang terdampak bencana.
"Mudah mudahan ini juga bisa membantu meringankan sekaligus juga mempercepat rangkaian proses pemulihan pasca bencana kemarin," tutur dia.
Di sisi lain, Kapolri mengatakan dirinya telah memerintahkan seluruh jajarannya untuk bergerak cepat membantu proses penanganan bencana dan masalah yang dialami masyarakat pasca kejadian tersebut.
"Kita sama-sama berdoa agar bencana ini segera bisa tertanggulangi," ujar dia.
Kapolri dan Ketua Komisi IV Salurkan 16 Truk Bantuan Kemanusiaan di Tapteng